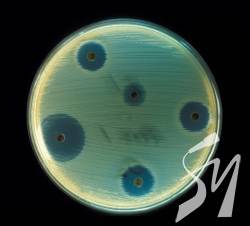
����������� ������ ���������

Антибиотики против ферментов
Ферменты важная составляющая каждого организма, это те самые полезные бактерии, которые необходимы для функционирования и стабильной работы наших внутренних органов. К сожалению современные методы лечения очень часто сводятся к приему антибиотиков вне зависимости от сложности и запущенности вашего конкретного случая.
Когда же антибиотик попадает в организм, он сметает на своем пути все бактерии, не разделяя их на “хорошие” или “плохие”.
Для тех, кто уже познал все “прелести” такой взаимосвязи знакома цепная реакция, после приема антибиотиков в первую очередь начинает страдать желудочно-кишечный тракт. Простые проблемы с запорами решают слабительные средства, однако их прием не всегда решает всю проблему в целом. Однако не стоит сразу же после окончания приема антибиотиков переходить на прием ферментов, и вот почему.
Самостоятельно выявить недостаток ферментов невозможно, для этого необходимо пройти соответствующие анализы, которые назначит вам врач. Однако к самому походу к врачу вас должны натолкнуть следующие симптомы: вздутие живота вне зависимости от того, насколько тяжелую пищу вы употребили, проблемы с калом, повышенное газообразование. После того как обследование выявило проблему вам могут назначить ферментные препараты, которые постепенно решают возникшие проблемы и стимулируют восстановление изначальной среды в желудочно-кишечном тракте.
.jpg)
Единого решения к данной проблеме нет, именно поэтому каждый отдельный случай рассматривается доктором и соответственно назначается курс лечения. Однако вместе с приемом лекарственных препаратов, необходимо брать и на себя долю ответственности и более осознанно подходить к своему питанию:
-
Дробное питание: довольно частая рекомендация от диетологов это поменять привычное трех-разовое питание и включить в него возможные перекусы. Так, голод будет менее сильным и вы не наброситесь на еду в основной прием пищи.
-
Кушать более медленно, а главное осознанно.
-
Не доедать с тарелки все, если вы уже почувствовали насыщение.
-
Есть на ночь менее тяжелую пищу, и забыть о правиле не есть после 18,00 - достаточно не кушать за 2 часа до сна.
Не очень здравый подход к происходящему нам диктует реклама, разрешающая наесться вволю за праздничным столом и решить эту проблему с помощью приема таблетки-фермента. Даже если она и способна решить эту проблему и снять тяжесть и вздутие живота, то это еще не повод злоупотреблять её возможностями.
| Версія для друку Відправити по e-mail Зв`язатися в чаті |
| Переглядів : 2758 |

















.jpeg)

































